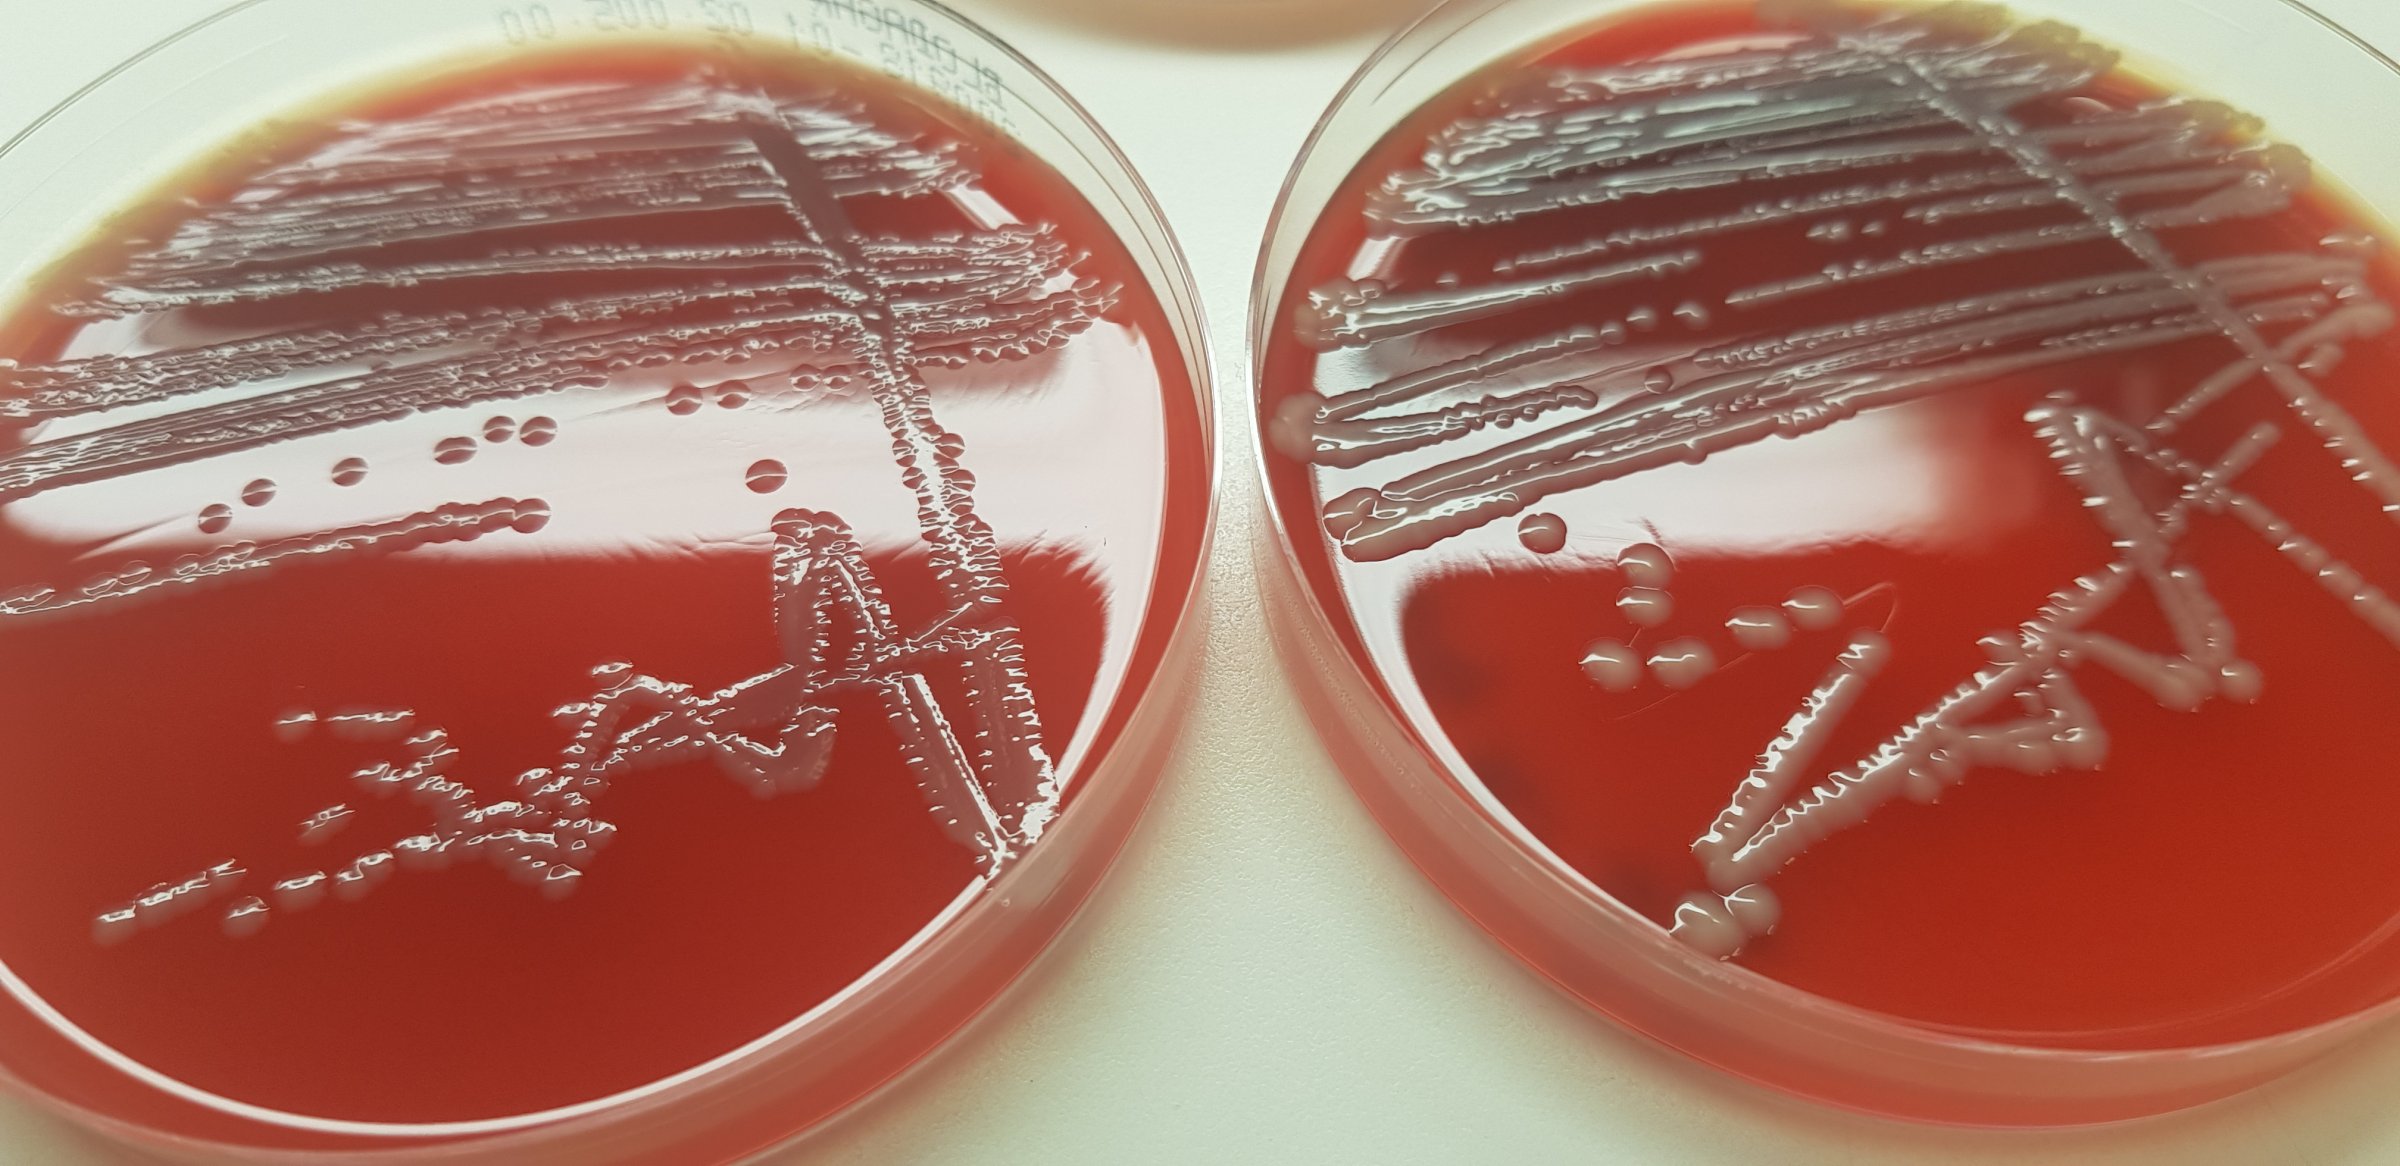

Har identifisert E. coli-varianter som gir høy første uke-dødelighet hos kyllinger
Inger Helene Kravik kan gjennom sin forskning identifisere varianter av E. coli som forårsaker systemisk infeksjon hos kyllinger og avdekker også risikofaktorer for første uke-dødelighet.

I Norge er målet å ha en dødelighet på under 0,8 prosent hos slaktekyllinger i deres første leveuke. I noen flokker forekommer det likevel en dødelighet på over 10 prosent. Som oftest på grunn av Colibacillose, en fellesbetegnelse på infeksjoner forårsaket av E. coli-varianten APEC. Colibacillose er ansett som en av de vanligste bakterielle sykdommene hos fjørfe på verdensbasis. Hos slaktekylling utarter sykdommen seg som oftest systemisk, og kalles coliseptikemi. Det er ikke uvanlig med høy første-uke dødelighet ved slike utbrudd.
Økonomi og dyrevelferd
-Det er både dyrevelferdsmessig og økonomisk viktig å få bukt med sykdomsproblematikken forårsaket av APEC, sier Inger Helene Kravik. Hun er forsker ved Veterinærinstituttet og har jobbet med temaet i sin doktorgradsavhandling ved NMBU Veterinærhøgskolen.
Etter en markant økning av tilfeller av slaktekyllingflokker med coliseptikemi i Norge og i de nordiske landene mellom 2014 og 2016 ble det klart at det manglet kunnskap om hvilke varianter av APEC som sirkulerer i den nordiske slaktekyllingpopulasjonen. På grunnlag av dette utbruddet ønsket næringen å få en oversikt over problemstillingen, og startet gjennom et forskningsprosjekt ledet av Veterinærinstituttet prøvetaking i 2018, frem til våren 2021.
-Målet med doktorgradsprosjektet har vært å bidra til økt kunnskap om APEC og om hvilke risikofaktorer som bidrar til den høye førsteuke-dødeligheten i flokker med spredning av E. coli-infeksjon. Prosjektet har vært et unikt samarbeidsprosjekt mellom forskere på Veterinærinstituttet og næringen, bestående av Nortura, Den Stolte Hane og Norsk Kylling, forklarer forskeren.
Nødvendig med prøver fra flere kyllinger
Forskere ved Veterinærinstituttet, ledet av Kravik, har systematisk samlet inn data og bakterieprøver fra slaktekyllingflokker opp til 14 dager gamle. Prøvene ble undersøkt ved å se på DNA-et fra 219 utvalgte APEC-isolater. Bakterieisolatene stammet fra til sammen 45 slaktekylling- og oppalsflokker med høy første-uke dødelighet.
Påviste høyvirulente APEC
Gjennom dette arbeidet identifiserte Kravik to varianter av APEC, som enkeltvis forårsaket sykdomsutbrudd på tvers av gårder i Norge.
– Avanserte analyser ga et viktig innblikk i hva vi kan forvente av genetiske likheter mellom APEC-isolater fra slike utbrudd, og hvilke gener som er forbundet med sykdom hos APEC, forklarer Kravik.
Risikofaktorer
En risikoanalyse viste en økt sannsynlighet på 233 prosent for første-uke dødelighet i flokken dersom forrige flokk i samme hus også hadde hatt problemer med høy første-uke dødelighet.
– Analysen viste også at en økning i flokken på 1000 fugler, uavhengig av tetthet, ville øke sannsynligheten for høy første-uke dødelighet med syv prosent. Resultatene fra studien gir viktig og utdypende informasjon om epidemiologien av APEC innad i norsk slaktekyllingproduksjon. Prosjektet har også bidratt til økt kunnskap og anbefalinger om nødvendig prøvetakings- og analysemetoder for utbruddsoppklaring, understreker Kravik.